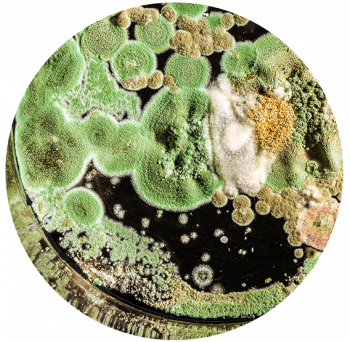

Allergoff
Airborne allergies are the most common allergies in the world.
The environment around us is full of allergic substances.
Contact with them may result in bothersome symptoms for the respiratory tract.
Groups of allergens which most frequently cause airborne allergies include:

House Dust Mites Allergens

A Variety of Different Pollens and Grasses

Pet Allergens
Fungal Spore Allergens
The Allergoff® range includes an Allergen Neutralising Spray and an Allergen Neutralising Washing Additive that help neutralise a range of airborne allergens that are found in the home environment. Allergoff® spray is recommended for use in areas of the house which are known to contain the highest levels of household dust allergens – specifically, mattresses, beds and other places where people sleep, quilts and pillows, upholstered furniture, carpets, rugs and curtains, and plush toys.
Allergoff® Wash removes allergens (including house dust mites) and facilitates the physical elimination of parasites that could be present in fabrics (such as fleas, ticks, lice and bedbugs) at a temperature below 60°C. It supports the treatment of inhaled allergy symptoms and infections of face mites (Demodex) and scabies (Sarcoptes scabei).
Allergoff® is safe for humans and pets
Allergoff® has passed toxicity and dermatological tests and has been positively assessed in clinical evaluations
Allergoff® has been certified by the National Institute of Public Health – Państwowy Zakład Higieny nr PZH/HT-2700/2012
The home allergy range also includes anti-allergy pillow covers, duvet covers and
mattress covers.

